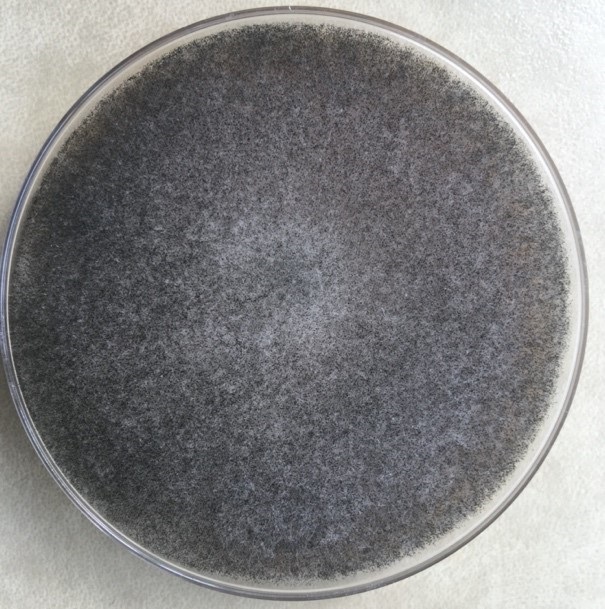
Imagen foto_00000003

Universidad de Valparaíso halla "hongo verde" en pacientes Covid que fueron ventilados
Infectólogo realizó estudio que involucró a cinco pacientes, pero en total la UV ha detectado 12 casos.
Su notificación no es obligatoria.
Estudio se llevó a cabo entre julio y septiembre de 2020.
El Centro de Diagnóstico e Investigación de Enfermedades Infecciosas de la Universidad de Valparaíso confirmó la presencia de un hongo verde en al menos 12 pacientes COVID de la región de Valparaíso que presentaron aspergilosis pulmonar.
Lo anterior quedó demostrado en un estudio que el director del recinto, doctor Rodrigo Cruz, publicó junto a un grupo de especialistas tras una investigación clínica realizada entre julio y septiembre de 2020, en la que se estudiaron cinco casos. Sin embargo, a la fecha otros siete casos han sido reportados por el centro.
"Como se trata de una enfermedad cuya notificación no es obligatoria, se desconoce el número exacto de casos. Pero hasta ahora se han reportado solo lo que indica nuestro estudio. Sin embargo, antes de la pandemia en nuestro país se describían esporádicamente algunos casos de mucormicosis y de aspergilosis pulmonar, porque se trata de infecciones provocadas por hongos invasores ubicuos, es decir, que se encuentran en todas partes. Pero casos asociados a pacientes con COVID-19 solo hemos tenido de aspergilosis", precisó Cruz.
Según explicó el infectólogo, ambas enfermedades tienen los mismos factores de riesgo y se ven más en pacientes diabéticos descompensados, inmunodeprimidos y oncohematológicos.
"En el caso de personas con COVID-19, la infección por ´hongo verde' se diagnostica a través de cultivos o mediante la detección del antígeno (galactomanano) que libera. Mayoritariamente se da en pulmones y en pacientes que llevan varias semanas conectados a ventilación mecánica y bajo tratamiento de corticoides", sostuvo el profesional.